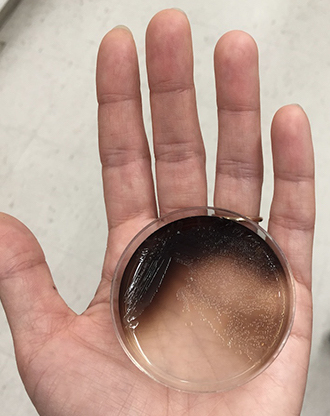

While an artist-in-residence at the Broad Institute of MIT and Harvard from 2018-2021, I developed a unique process for creating images with melanin produced by live, genetically-modified bacteria cells.
Melanin is the main pigment behind human skin, hair, and eye color. I am considering what might happen when the visibility of an image is created through the key pigment behind human appearance through a living process. As a signifier for race and identity, melanin, and the biological process that forms each image, questions the use of vision to justify social constructs.
MORE ABOUT THE PROCESS ↓

Hands Pollinating Vanilla Flowers (Edmond Albius Method)
Melanin produced by genetically modified E. coli cells on paper, powder-coated aluminum brackets
Installation view, Henry Art Gallery, University of Washington, Seattle
163 in. x 126 in.
2024

Vanilla Orchid Pods (V. Planifolia) #1
Melanin produced by genetically modified E.coli cells on paper
43.5” x 19.5 “
2023

Vanilla Orchid Pods (V. Planifolia) #3
Melanin produced by genetically modified E.coli cells on paper
43.5” x 19.5 “
2023

Jade Grapes #3 (1/29/23 Printing) and Jade Grapes #1 (1/22/23 Printing)
Melanin produced by genetically modified E. coli cells on paper
62 x 44 in.
2023

Malik with Toy Eyeballs
Melanin produced by genetically modified E. coli cells on paper
17 x 13 in.
2020

Soo and Hanna #2 (8/7/22 Printing)
Melanin produced by genetically modified E. coli cells on paper
44 x 36 in.
2022

Phalaenopsis (like a moth) #1
Melanin produced by genetically modified E. coli cells on paper
44 x 36 in.
2022

Phalaenopsis (like a moth) #4
Melanin produced by genetically modified E. coli cells on paper
44 x 36 in.
2022

Tree, Maui Rainforest #3
Melanin produced by genetically modified E. coli cells on paper
46 x 36 in.
2022

Open Screen #1 (8/21/22 Printing)
Melanin produced by genetically modified E. coli cells on paper
44 x 36 in.
2022

Open Screen #4 (8/1/22 Printing)
Melanin produced by genetically modified E. coli cells on paper
44 x 36 in.
2022

Melanin Test Print (Hanna #3)
Melanin produced by genetically modified E. coli cells on paper
17x13 in.
2021

Malik #3, 2022
Melanin produced by genetically modified E. coli cells on paper
22 x 32 in.
2022

Jade Grapes #1 (3/8/22 Printing)
Melanin produced by genetically modified E. coli cells on paper
18.5 x 13 in.
2022

Jade Grapes #1 (6/7/22 Printing)
Melanin produced by genetically modified E. coli cells on paper
18.5 x 13 in.
2022
PROCESS
I began looking into melanin as a material in 2015 when I was painting bright colors onto resin casts of human skin for my sculptural paintings. I wondered if it would be possible to make oil paints out of the pigments responsible for human coloration. At the time, I believed that there would be numerous pigments but I soon learned that there are two: eumelanin, which is black/brown and the most ubiquitous, and pheomelanin, which is red and colors red hair. For example, there is no separate pigment that causes blue eyes, which owe their color to the way light reflects back out from the iris. As eumelanin in the iris interacts with reflecting light, eye color changes.

Melanin in powder form, purchased from Sigma-Aldrich.
Melanin made by genetically modified E. coli cells in petri dish.
"The most important pigment in the animal kingdom, eumelanin both protects the body and gives it color. "
—Nina G. Jablonski, from "Living Color: The Biological and Social Meaning of Skin Color"
"Social practices at once constitute the ability to see race while, at the same time, hiding themselves so that race is experienced at an individual level as visually obvious; race becomes simply what is seen. Part of the difficulty in “revealing” these practices is the seductive nature of vision and the significant role it plays in how we understand the social world. Seeing is believing, so to speak, which often leaves race analyses to go no further than what is superficially observed."
—Osagie Obasogie, from "Blinded by Sight: Seeing Race Through the Eyes of the Blind"
—Nina G. Jablonski, from "Living Color: The Biological and Social Meaning of Skin Color"
"Social practices at once constitute the ability to see race while, at the same time, hiding themselves so that race is experienced at an individual level as visually obvious; race becomes simply what is seen. Part of the difficulty in “revealing” these practices is the seductive nature of vision and the significant role it plays in how we understand the social world. Seeing is believing, so to speak, which often leaves race analyses to go no further than what is superficially observed."
—Osagie Obasogie, from "Blinded by Sight: Seeing Race Through the Eyes of the Blind"

Tubes of agar media with different concentrations of melanin. The darker the tube, the higher the amount of melanin.
It has taken me three years to develop this process, and I am continuously refining it as I build this project. To create the prints, I screen-print live, genetically modified E. coli cells directly onto paper, and place them in an incubator. As the cells are translucent and the paper is white, the image becomes legible as the cells produce melanin.
The 30 second video above is a time-lapse of the live bacteria cells making melanin on paper. As the melanin appears, so does the image, as well as the distortions caused by the cells being living organisms responding to their environment. The image is alive and continues to develop until the cells are killed.
When live bacteria is printed onto paper, the cells respond to minute differences in conditions across the paper’s surface. There are tonal variations caused by the cells as they respond to shifts in moisture level, chemical composition, and paper texture. There is also evolutionary drift of the cells as they rapidly reproduce, which changes how much melanin each cell produces (under ideal conditions, E. coli cells double every 20 minutes). Add in the inconsistencies of the human hand to this microscopic biological process, and the result is a unique print.

An example of a melanin print showing the living process of the bacteria cells: The cells were printed to form a flat rectangle, but resulted in this galaxy-like image. Hand included to show scale and focus.

First successful melanin test prints on paper, created with a strain developed by Dr. Guillermo Gosset (UNAM, Mexico) and the help of Dr. Sam Myers during Kim’s artist residency at the Broad Institute of MIT and Harvard, 2019.
A short video about the project produced by the Broad Institute of MIT and Harvard.
A short video about the project produced by Boston University, where I teach and where the project has been based since 2020.

Lucy Kim and lab assistant Abby Fenn screen-printing live, genetically-modified E. coli cells onto paper. Cells are suspended in an ink recipe developed by Kim. Location: Boston University Biology Department (Celenza Lab), 2022.

Melanin prints incubating, Boston University Biology Department, 2022

Checking on large incubating melanin prints (Lucy Kim, Boston University Biology Department), 2022.
Photo: Anh Nguyen

This project would not be possible without the generous support of, and collaboration with, many people and institutions:
Broad Institute Artist-in-Residence ProgramBoston University Biology Department
Boston University School of Visual Arts
Creative Capital
Howard Foundation Fellowship
Boston University’s Undergraduate Research Opportunities Program (UROP)
Dr. Guillermo Gosset (UNAM, Mexico), who developed the E. coli strain
Dr. Chip Celenza (Boston University Biology Department)
Dr. Sam Myers (formerly at the Broad Institute, now at La Jolla Institute, CA)
Maria Brym (University of Florida)
Abby Fenn (Former student, now my studio and lab assistant)
And all the incredible Boston University students who are currently, or have been, involved in this project (Xian Boles, Mason Burns, Abby Fenn, Brianna Howard, Allison Huang, Eli Ibarra, Rylee Malone, Jaylynn McCurdy, Sanjana Prudhvi, Bridgette Reilly, Allison Suarez, and Xingpei Zhang)
From the bottom of my heart, thank you.



Jaylynn McCurdy (Neuroscience ‘25) making solutions.


Rylee Malone (Bio ‘22), Sanjana Prudhvi (Bio ‘24), and Brianna Howard (Painting ‘22) with their E.coli cultures.
